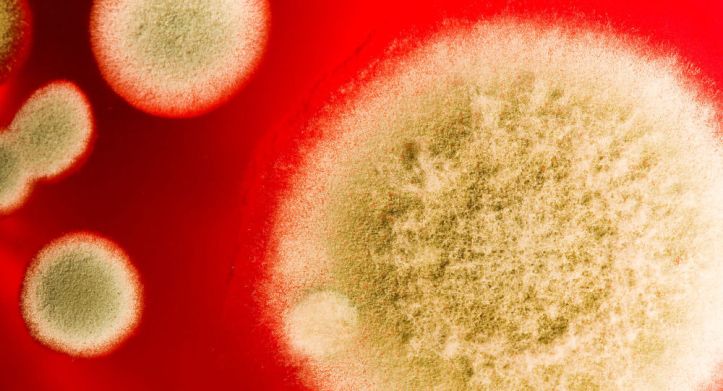
Funghi su Marte

I ricercatori della NASA stanno studiando il potenziale dei miceli – l’apparato vegetativo dei funghi, quella massa di filamenti sottili detti ife, che assorbono i nutrienti e che costituiscono la gran parte della massa del fungo. Questo secondo gli scienziati potrebbe contribuire in maniera sostanziale a realizzare gli avamposti sulla Luna e su Marte.
